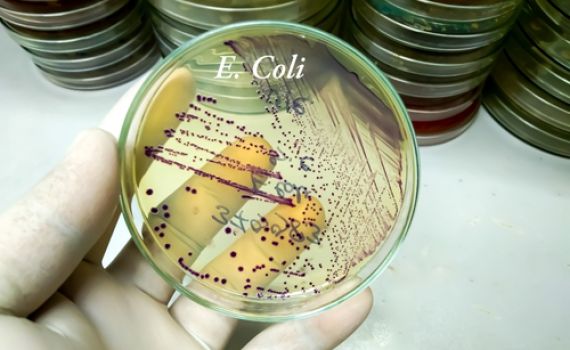
זיהום מסכן חיים מתפשט בישראל. אלו התסמינים

התפרצות חריגה בישראל של תסמונת בשם "סינדרום המוליטי" שגורם להרס תאי דם, הפרעות בקרישה ופגיעה בכליות, כך מפרסם ד"ר איתי גל באתר 'מעריב'. על פי הפרסום, עד כה חלו בתסמונת הנדירה 26 ישראלים במהלך 2024.
במשרד הבריאות חושדים כי המקרים קשורים לזיהום בחיידק הצואתי אי-קולי המפריש רעלן מסוכן. הזיהום ככל הנראה נגרם מהיגיינה ירודה או מצריכת מזון מזוהם, ובמיוחד בשר שאינו מבושל היטב או ירקות ופירות שלא נשטפו כראוי.
על פי הפרסום של ד"ר גל, התסמינים של המחלה כוללים שלשול דמי, כאבי בטן, הקאות, חולשה, ירידה במתן שתן ותסמינים של אי-ספיקת כליות כמו בצקות ויתר לחץ דם. האבחון מבוסס על בדיקות דם שמגלות חסר דם בשל הרס תאי דם אדומים, מחסור בטסיות דם, ופגיעה חמורה בכליות.
במשרד הבריאות ציינו כי הם פועלים להעמיק את החקירה האפידמיולוגית ולזהות את מקורות ההדבקה על מנת למנוע התפרצות נוספת

מה דעתך בנושא?
0 תגובות
0 דיונים